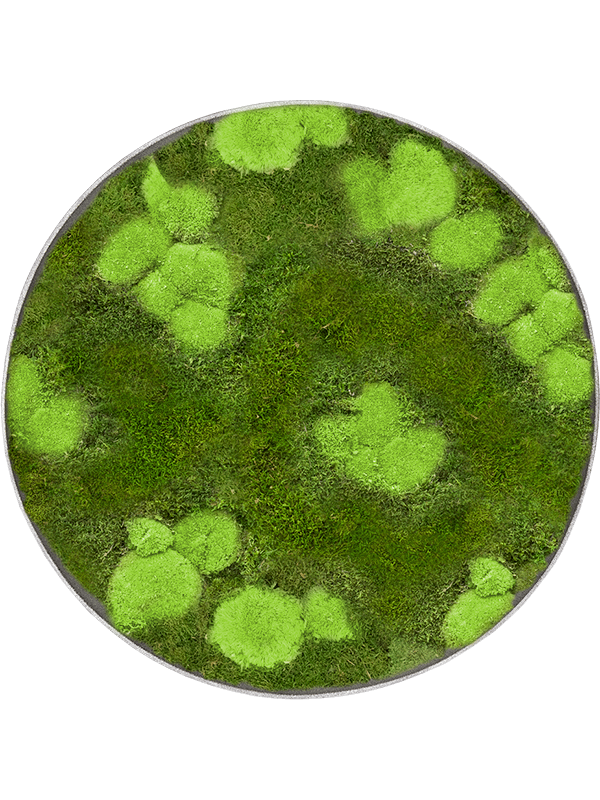

Mahaloplants
Moosbild
Moosbild
Niedriger Lagerbestand: 3 verbleibend
Verfügbarkeit für Abholungen konnte nicht geladen werden
Grösse
Grösse
5 cm
Topfdurchmesser
Topfdurchmesser
30 cm
Spezifikationen
Spezifikationen
- Pflanzensorte: Islandmoos
- Lichtbedürfnisse: keine
- Lebensdauer: mehrjährig
- Bewässerung: keine
- Düngen:
- Ursprungsland:
- Artikelnummer: 1199999
Pflegeanleitung
Moosbild – Natürlich. Stilvoll. Pflegefrei.
Unsere Moosbilder bestehen aus hochwertigem, nachhaltig gezüchtetem Moos und bringen die beruhigende Kraft der Natur direkt an deine Wand – ganz ohne Pflegeaufwand.
Jedes Bild ist ein Unikat aus sorgfältig konserviertem Moos in Premiumqualität. Es bleibt dauerhaft weich, grün und lebendig – ganz ohne Wasser, Licht oder besondere Pflege.
Ob im Wohnzimmer, Büro oder Eingangsbereich: Das Moosbild schafft ein natürliches Ambiente, verbessert die Raumakustik und setzt stilvolle Akzente.
Und wie immer bei MahaloPlants: Lebenslanger Support – auch bei pflegefreien Kunstwerken.
Bring die Natur nach drinnen – nachhaltig, elegant und ganz entspannt.
Share

Subscribe to our emails
Be the first to know about new collections and exclusive offers.